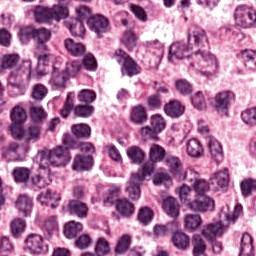
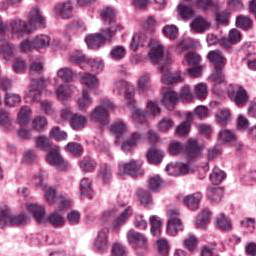
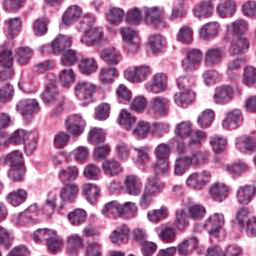

Anomaly detection is the problem of recognizing abnormal inputs based on the seen examples of normal data. Despite recent advances of deep learning in recognizing image anomalies, these methods still prove incapable of handling complex medical images, such as barely visible abnormalities in chest X-rays and metastases in lymph nodes. To address this problem, we introduce a new powerful method of image anomaly detection. It relies on the classical autoencoder approach with a re-designed training pipeline to handle high-resolution, complex images and a robust way of computing an image abnormality score. We revisit the very problem statement of fully unsupervised anomaly detection, where no abnormal examples at all are provided during the model setup. We propose to relax this unrealistic assumption by using a very small number of anomalies of confined variability merely to initiate the search of hyperparameters of the model. We evaluate our solution on natural image datasets with a known benchmark, as well as on two medical datasets containing radiology and digital pathology images. The proposed approach suggests a new strong baseline for image anomaly detection and outperforms state-of-the-art approaches in complex medical image analysis tasks.
翻译:异常检测是根据正常数据实例识别异常输入的问题。尽管在识别图像异常方面最近取得了深层次学习的进展,但这些方法仍然证明无法处理复杂的医学图像,如胸部X光几乎看不到异常和淋巴节点转移等。为了解决这一问题,我们引入了一种新的强有力的图像异常检测方法。它依靠古典的自动解剖器方法,经过重新设计的培训管道来处理高分辨率、复杂图像和图像异常分数。我们重新审视了完全不受监督的异常点检测的非常问题说明,在模型设置期间,根本没有提供异常的例子。我们提议放松这一不现实的假设,仅使用少量有限的异常点来开始搜索模型的超参数。我们评估我们使用已知基准的天然图像数据集以及包含放射学和数字病理图像的两个医疗数据集的解决方案。拟议方法为在复杂的医学图像分析任务中,为图像异常点检测和超常规状态方法提供了新的强基线。